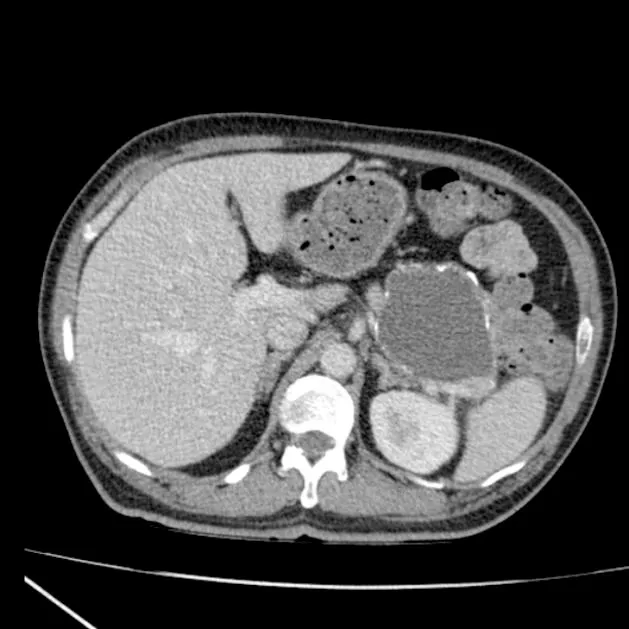
Large pancreatic pseudocyst on CT scan

Pancreatic Cysts - First, Rule Out Fakes!
- Pancreatic cysts: Broadly non-neoplastic (e.g., pseudocysts) or neoplastic.
- Pseudocysts: Most common (75-80%). Not true cysts. 📌 Pseudo = False lining.
- Lack epithelial lining; wall of fibrous/granulation tissue.
- Caused by pancreatitis, trauma, surgery.
- Symptoms: Pain, mass effect, or asymptomatic.
- Complications: Infection, hemorrhage, rupture.
- Key: Differentiate from neoplastic cysts (MCN, SCN, IPMN).
⭐ Pseudocysts are distinguished by the ABSENCE of an epithelial lining, unlike true cysts which possess one.
Serous Cysts - Grandma's Benign Bubbles
-
Benign cystic neoplasm, typically in women >60 yrs (📌 "Grandma" lesion).
-
Location: Predominantly pancreatic body/tail.
-
Gross: Multiloculated, microcystic ("honeycomb" or "spongy" pattern).
- Often has a central, stellate fibrous scar (may show calcification).
-
Microscopy: Cysts lined by clear, cuboidal, glycogen-rich epithelial cells (PAS+).
-
Genetics: Associated with Von Hippel-Lindau (VHL) gene mutations.
⭐ Serous cystadenomas are virtually always benign; malignant potential is extremely low.
Mucin Monsters - Stroma & Duct Dilemmas
Two key mucinous cysts with malignant potential: Mucinous Cystic Neoplasm (MCN) & Intraductal Papillary Mucinous Neoplasm (IPMN). Differentiating them is crucial.
-
Mucinous Cystic Neoplasm (MCN):
- Predominantly in women (95%); body/tail of pancreas.
- NO communication with pancreatic duct system.
- Hallmark: Ovarian-type stroma (pathognomonic).
- Cyst fluid: ↑CEA common.
- Management: Surgical resection generally advised.
-
Intraductal Papillary Mucinous Neoplasm (IPMN):
- Originates from pancreatic duct epithelium; communicates with ducts.
- Typically older males; pancreatic head common.
- Types:
- Main Duct (MD-IPMN): MPD dilated >5mm (often ≥10mm for high-risk); high malignant risk.
- Branch Duct (BD-IPMN): Cystic dilations of side branches; lower risk.
- Mixed Type: Involves both; behaves like MD-IPMN.
- 📌 Involves Pancreatic Main Network (IPMN connects to ducts).

⭐ Fukuoka guidelines critical for IPMN: Resect MD-IPMNs & BD-IPMNs with high-risk stigmata (mural nodule ≥5mm, MPD ≥10mm, jaundice).
SPN Surprises - Young & Enigmatic
- Aka: Solid Pseudopapillary Neoplasm (SPN), Frantz tumor.
- Epidemiology: Predominantly young females (20-30 years); F:M >10:1.
- Location: Often pancreatic body or tail.
- Nature: Low-grade malignant potential; excellent prognosis with complete resection.
- Gross: Well-circumscribed, encapsulated mass; solid and cystic components with hemorrhage and necrosis.

- Microscopy: Characteristic pseudopapillae; cells with uniform nuclei, eosinophilic cytoplasm; hyaline globules.
- IHC: Nuclear β-catenin+, Vimentin+, CD10+, CD56+, PR+.
⭐ Genetic Signature: Activating mutations in the CTNNB1 gene (encoding β-catenin) are nearly universal.
Cystic Face-Off - Clues & Choices
- SCA: Elderly F; microcystic ("honeycomb"); central scar; ↓CEA. Benign.
- MCN: Middle-aged F (95%); body/tail; ovarian stroma; ↑CEA. Resect (premalignant).
- IPMN: Elderly M; duct link; ↑CEA, ↑Amylase. MD-IPMN (resect); BD-IPMN (surveil/resect based on risk).
- SPN: Young F; solid & cystic; hemorrhagic. Resect (low-grade malignancy).
⭐ > MCNs almost exclusively occur in women and are characterized by ovarian-type stroma.
High‑Yield Points - ⚡ Biggest Takeaways
- Serous Cystadenoma (SCA): Benign, glycogen-rich cells, central scar, elderly women.
- Mucinous Cystic Neoplasm (MCN): Exclusively women, ovarian stroma, body/tail, premalignant.
- Intraductal Papillary Mucinous Neoplasm (IPMN): Involves ducts, older men, malignant potential; main duct IPMN is higher risk.
- Solid Pseudopapillary Neoplasm (SPN): Young women, low malignant potential, CTNNB1 mutations.
- Pancreatic Pseudocysts: Most common, no epithelial lining, history of pancreatitis.
- High CEA in MCN/IPMN; low in SCA.
Unlock the full lesson and continue reading
Signup to continue reading this lesson and unlimited access questions, flashcards, AI notes, and more